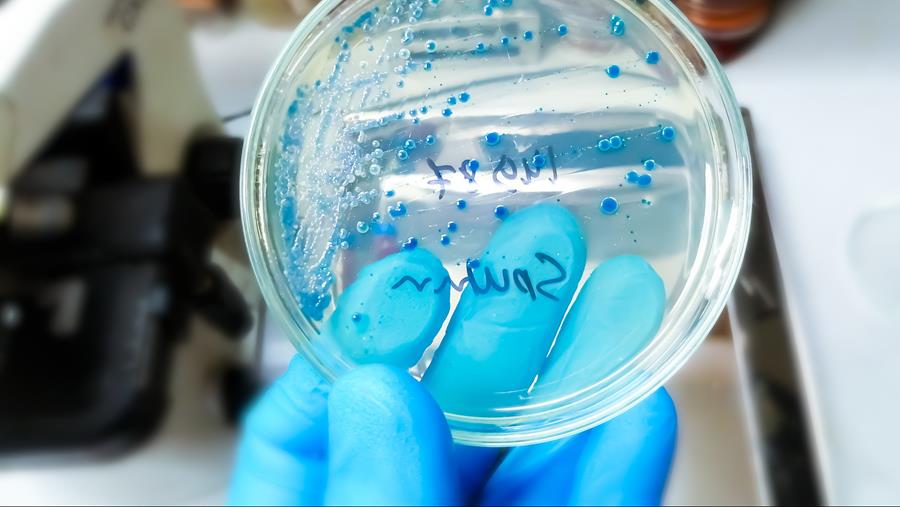
Resolutie wil pneumokokkenvaccinatie veralgemenen

- 09 december 2025
- Door Herman Nys
- | Bron: Artsenkrant
Resolutie wil pneumokokkenvaccinatie veralgemenen
Volksvertegenwoordigers Kathleen Depoorter c.s. (N-VA) dienden bij de Kamer van Volksvertegenwoordigers een voorstel van resolutie in ‘strekkende tot een alomvattende vaccinatie tegen pneumokokkeninfecties.
Gratis dit artikel lezen?
Registreer en word gratis online abonnee
Ben je al abonnee?
Meld je aan en krijg toegang tot de website
Door te registreren ontvangt u de newsletter. De newsletter kan u te allen tijde en zonder verdere formaliteiten opzeggen. Wij garanderen u dat uw e-mailadres en andere persoonlijke gegevens nooit aan derden worden doorgegeven en enkel gebruikt worden voor het versturen van de newsletter.
Door u in te schrijven, gaat u akkoord met De privacyvoorwaarden.